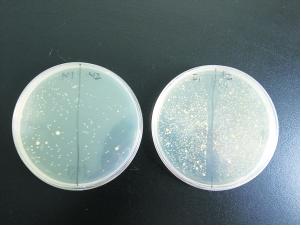
14678946085353.jpg

很多人認為,吃不完的食物封上保鮮膜再放入冰箱,既安全又衛生。事實上,並不是所有食物都適合用保鮮膜保存,比如夏天最熱銷的西瓜。

實驗發現,將西瓜蓋上保鮮膜後放入冰箱,滋生的細菌反而比沒保鮮膜的多。專家解釋,因為保鮮膜阻礙了西瓜降溫,給細菌繁殖提供了條件。

專家說:「如果細菌的毒性大,那麼即使數量不多的細菌也能致病。」輕則腹瀉,嚴重的話可能造成食物中毒。
| sponsored ads |
|
|
| sponsored ads |
據研究,因為西瓜在蓋保鮮膜之前,表面就存在細菌和微生物,保鮮膜的透氣功能又不好,導致西瓜溫度下降速度變慢,使得細菌繁殖得更快,就很容易變質。

雖然有些專家對於這樣的說法不以為然,認為在西瓜切開到保存的過程中,細菌的來源包括砧板、刀子、人們的手等等,因此實驗不具備準確性。
但無論如何,最好的保鮮,就是在儘可能短的時間內食用。專家建議:「保鮮盒在保持水分的同時還能保持食物的味道,所以如果是保存熟食,更好的選擇是用保鮮盒。」

所以說,以後我還是把西瓜整顆拿起來啃最棒了!快把這個新知識分享給朋友們吧!
|
